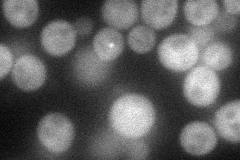
YCR008W
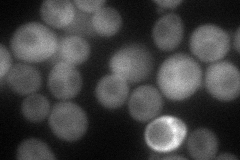
YCR008W
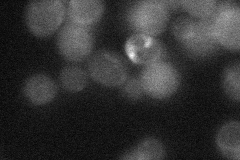
YCR008W
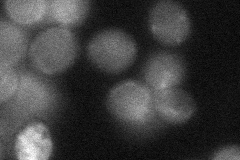
YCR008W
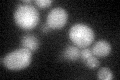
YCR008W
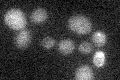
YCR008W

View description
Ser/Thr protein kinase involved in salt tolerance; funtions in regulation of Trk1p-Trk2p potassium transporter; partially redundant with Hal5p; has similarity to Npr1p
Localization:
Intensity:
Fold change:
Significance:
-
C’ GFP library in SD

below threshold17.06 -
N' NOP1pr-GFP in SD
cytosol57.607 -
N' TEF2pr-mCherry in SD
cytosol60.732 -
N' NATIVEpr-GFP in SD
cytosol28.0726 -
N' TEF2pr-VC and Cyto-VN in SD
cytosol32.1138 -
C’ GFP library in SD+DTT
cytosol16.490.96No -
C’ GFP library in SD+H2O2

cytosol20.431.19No -
C’ GFP library in Starvation Media
cytosol16.570.97No -
C’ GFP library on the background of Pup2-DaMP

below threshold -
C’ GFP library on the background of CCT mutant

below threshold17.96351.05244No
